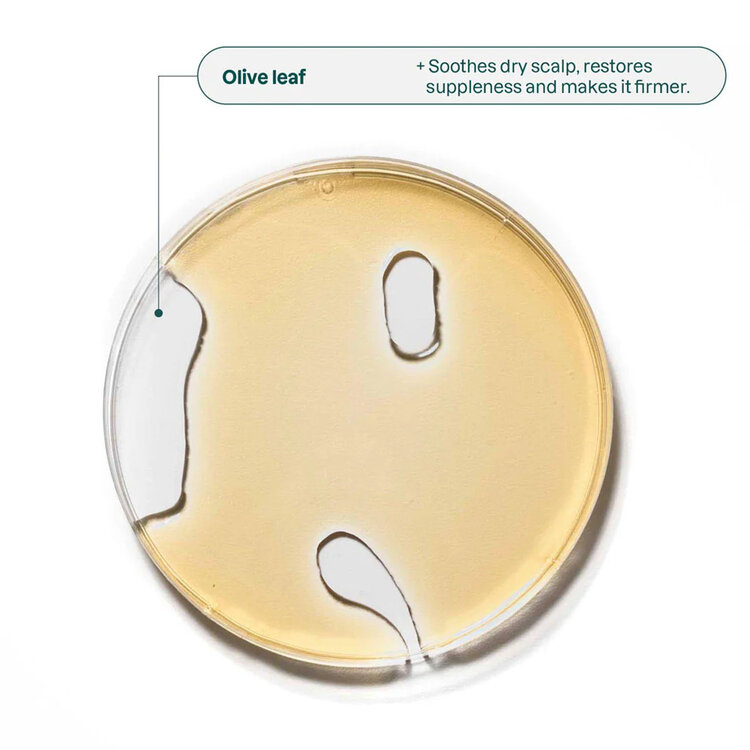

DESCRIPTION
Nourris et hydrate tes cheveux secs ou abîmés avec le Revitalisant Nourrissant Super Leaves d’Attitude. Sa formule enrichie en feuilles de capucine, cresson de fontaine et feuilles d’olivier répare ta fibre capillaire tout en laissant tes cheveux doux, brillants et super faciles à coiffer. Sa texture légère pénètre vite sans jamais alourdir, pour un soin efficace, naturel et respectueux de ta chevelure comme de la planète.
-
Hydrate et nourrit intensément les cheveux secs
-
Répare et renforce la fibre capillaire
-
Laisse les cheveux doux, brillants et faciles à coiffer
-
Formule végane, biodégradable et sans ingrédients nocifs
-
Sans sulfates, parabènes, silicones ni PEG
-
Certifié EWG Verified™ et ECOLOGO®
UTILISATION
Après le shampooing, applique une noisette de Revitalisant Nourrissant Super Leaves d’Attitude sur tes longueurs et pointes. Laisse-le agir quelques instants pour bien nourrir tes cheveux, puis rince soigneusement. Résultat ? Des cheveux doux, faciles à démêler et prêts à briller toute la journée. Simple, rapide et efficace !
INGRÉDIENTS
Aqua / Water / Eau • Cetearyl Alcohol • Glycerin • Caprylic/Capric Triglyceride • Behentrimonium Methosulfate • Cetyl Stearyl Alcohol • Tapioca Starch • Vitis Vinifera (Grape) Seed Oil • Butyrospermum Parkii (Shea) Butter • Dicaprylyl Ether • Sodium Benzoate • Potassium Sorbate • Limonene • Citrus Aurantium Dulcis (Orange) Peel Oil • Citric Acid • Citrus Aurantium Bergamia (Bergamot) Peel Oil • Olea Europaea (Olive) Leaf Extract • Citrus Grandis (Grapefruit) Peel Oil • Pogostemon Cablin Leaf Oil • Nasturtium Officinale Extract • Tropaeolum Majus Flower/Leaf Extract • Cananga Odorata Flower Oil • Sodium Hydroxide